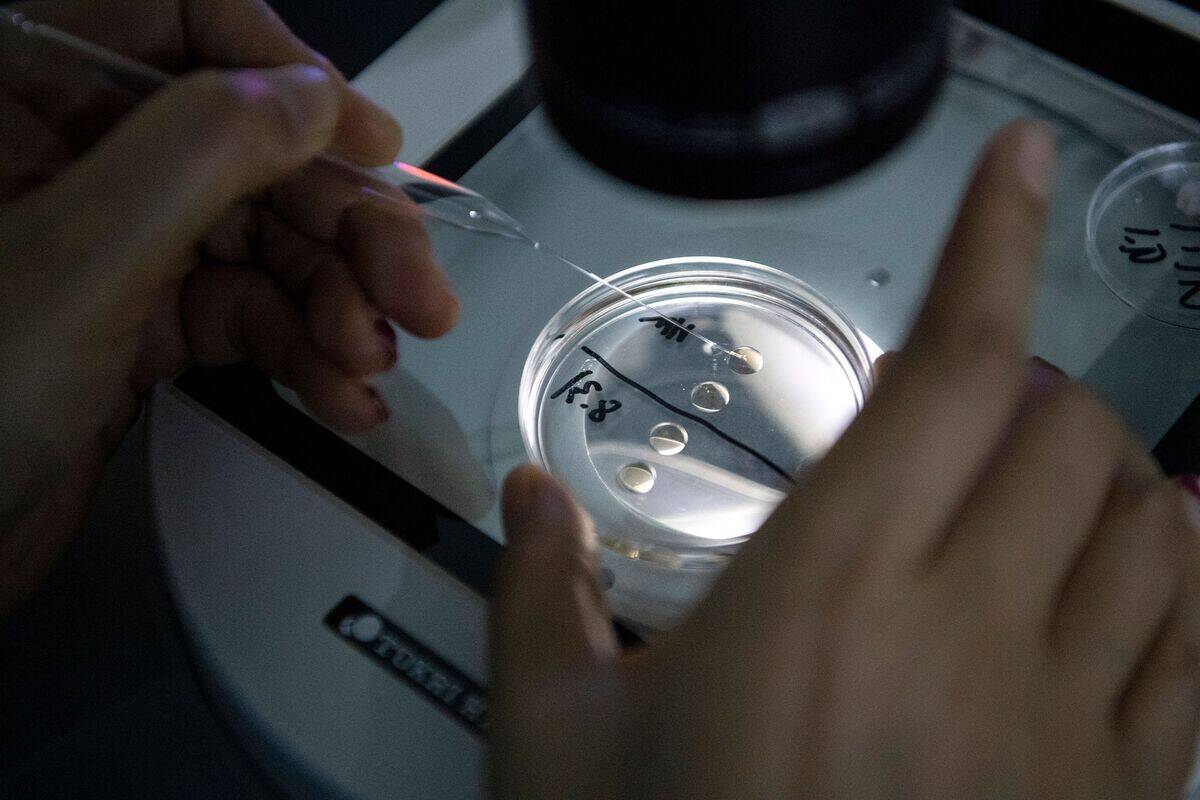
CHINA-SCIENCE-LIFESTYLE

How science seeks to restore extinct species’ traits
Imagine a world where creatures of the past could once again roam the Earth. The concept of de-extinction, the process of reviving extinct species, captivates the imagination.
Scientists worldwide are exploring the possibilities of bringing back species lost to time, from majestic woolly mammoths to the once-flourishing passenger pigeons. With advancements in genetic technologies, what was once pure science fiction is now edging closer to reality, sparking debates and excitement across the globe.
A Brief History of Extinct Species and Their Impact on Earth

Earth has seen the rise and fall of many species, each leaving a unique mark on the planet. The dodo, native to Mauritius, was driven to extinction by the 17th century due to human activity. Its disappearance serves as a poignant reminder of our impact on ecosystems.
Similarly, the passenger pigeon, once numbering in billions, vanished in the early 20th century. Extinct species have shaped the world we know, influencing biodiversity and ecological balance in profound ways.
The Science Behind De-Extinction: An Overview

De-extinction combines cutting-edge science with a touch of the miraculous. At its core, de-extinction research involves recovering fragmented DNA from preserved specimens and using genetic engineering or selective breeding with closely related living species to recreate some traits of extinct organisms.
Scientists use advanced techniques such as cloning and genetic engineering to attempt the revival of these lost creatures. This genetic material serves as the blueprint, guiding researchers in their quest to resurrect species that once roamed our planet.
Jurassic Park or Reality? The Ethics of Bringing Back Extinct Species

The idea of de-extinction stirs up images of dinosaurs roaming wild, à la Jurassic Park. But the ethical considerations are far more complex. Critics argue that resources could be better spent on conserving existing species rather than resurrecting the past.
There’s also the question of ecological impact—could reintroduced species disrupt current ecosystems? However, proponents believe de-extinction could aid biodiversity and repair past human-caused extinctions, presenting a moral obligation to explore these possibilities.
DNA: The Building Block for Resurrecting Lost Traits

DNA is the cornerstone of de-extinction, holding the secrets of lost species within its double helix. Scientists extract DNA fragments from preserved remains, which can be decades, or even centuries old.
While ancient DNA is often degraded, modern techniques allow researchers to piece together these genetic puzzles. By comparing recovered DNA with that of living relatives, scientists can identify and reconstruct the necessary traits, opening the door to reviving species thought lost forever.
Cloning: The Process of Creating a Genetic Duplicate

Cloning is a fundamental tool in the de-extinction toolkit, offering the potential to create a genetic duplicate of extinct species. The process involves transferring the nucleus of a cell from the extinct species into an egg cell of a closely related living species.
This egg is then stimulated to develop into an embryo. While successful cloning has seen breakthroughs, such as cloning the Pyrenean ibex in 2003, the challenges remain significant, including high failure rates and ethical concerns.
The Role of Genetic Engineering in De-Extinction

Genetic engineering takes de-extinction a step further by actively modifying DNA to recreate extinct species. Using tools like CRISPR, scientists can edit genes with precision, inserting traits from extinct animals into the genomes of living relatives.
This technique is particularly useful when cloning is not feasible due to degraded DNA. By tweaking the genetic makeup, researchers hope to bring back species like the woolly mammoth by engineering elephants with mammoth-like characteristics.
Selective Breeding: A Method to Revive Ancient Traits

Selective breeding offers a more traditional approach to de-extinction, utilizing the natural genetic diversity within a species. By selectively breeding individuals with traits similar to extinct species, scientists can gradually revive certain characteristics.
This method was used to create the Heck cattle in the 20th century, an attempt to recreate the aurochs, a wild ancestor of domestic cattle. While not a perfect replica, selective breeding provides a viable path to restoring traits lost over generations.
The Woolly Mammoth: A Case Study in De-Extinction Efforts

The woolly mammoth has become a poster child for de-extinction. Researchers aim to revive this iconic Ice Age creature by using DNA from well-preserved specimens found in Siberian permafrost.
By editing elephant DNA to include mammoth genes, scientists hope to create a hybrid species capable of thriving in Arctic environments. The project not only seeks to bring back a lost species but also to restore the tundra ecosystem, potentially mitigating climate change by promoting grassland growth.
Passenger Pigeon: A Flight Towards Revival

The passenger pigeon, once a symbol of abundance, now represents lost opportunities. De-extinction efforts for this bird focus on using genetic engineering to reintroduce its traits into living band-tailed pigeons, a close relative.
By sequencing the passenger pigeon’s genome, scientists have identified key genes responsible for its unique features. The goal is to create genetically modified proxies resembling passenger pigeons by editing the genomes of close relatives, with the long-term possibility of studying whether such birds could fulfill some historical ecological roles in modern forests.
Tasmanian Tiger: Hopes for a Second Chance

The Tasmanian tiger, or thylacine, has intrigued scientists and conservationists due to its recent extinction in the 1930s. Hopes for its revival hinge on advances in genetic technologies. Researchers have sequenced the thylacine genome, providing an important foundation for studying its biology and exploring theoretical de-extinction approaches, though practical revival remains highly uncertain.
While many challenges remain, including finding suitable surrogates, the project has ignited public interest and debate about the feasibility and desirability of bringing back such a unique predator to its natural habitat.
Challenges and Limitations of Current Technologies
While the prospect of de-extinction is exciting, it comes with significant challenges. Current technologies still face limitations, such as incomplete DNA sequences, high costs, and ethical dilemmas. The process of cloning is fraught with technical difficulties, including low success rates and health issues in cloned animals.
Moreover, the ecological implications of reintroducing species remain largely unknown. Addressing these challenges requires continued research and dialogue to ensure responsible and effective de-extinction practices.
Biodiversity and Ecosystem Restoration: Potential Benefits

De-extinction holds the promise of revitalizing ecosystems and enhancing biodiversity. By reintroducing species that played crucial ecological roles, such as seed dispersal or predator-prey dynamics, scientists hope to restore balance to disrupted environments.
For example, bringing back the woolly mammoth could help transform Arctic landscapes, promoting grassland growth and reducing carbon emissions. These potential benefits highlight the importance of considering de-extinction as a tool for ecological restoration and sustainability.



